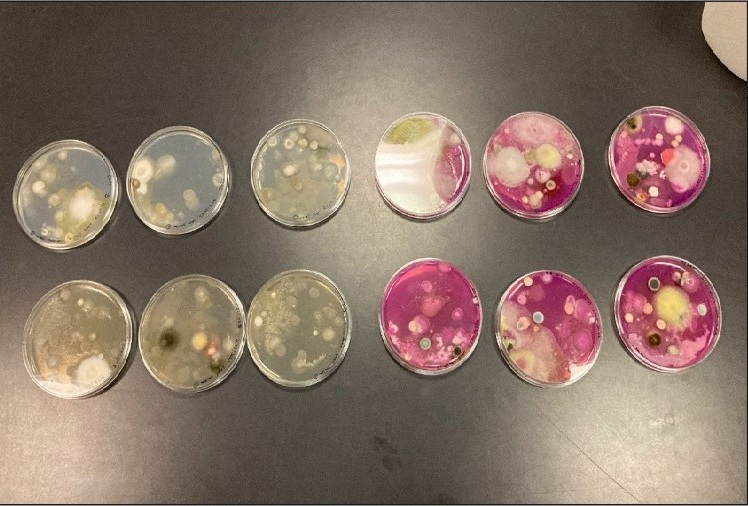

Üniversitemizin Mühendislik Fakültesi Jeoloji Mühendisliği Bölümü öğretim üyelerinden Doç. Dr. Ezher Tagliasacchi, Türkiye Bilimsel ve Teknolojik Araştırma Kurumu (TÜBİTAK) Bilim İnsanı Destek Programları Başkanlığı tarafından yürütülmekte olan 2219 Yurt Dışı Doktora Sonrası Araştırma Burs Programı kapsamında desteklenmeye hak kazanmıştır.
Bu çerçevede Doç. Dr. Tagliasacchi, “Ekstrem Ortamlarda Alkali Toleranslı Fungusların Tanımlanması ve Jeolojik Süreçlerdeki Rolleri (Jeomikoloji): Örnek Çalışma Salda Gölü, Burdur (GB-Türkiye)” başlıklı projesini (Proje No: 1059B192401056), 30 Haziran 2025 tarihinden itibaren İtalya Cenova Üniversitesi (University of Genoa, Italy) bünyesinde yer alan DISTAV (Yer Bilimleri, Çevre ve Yaşam Bilimleri) Fakültesi, Mikoloji Laboratuvarı’nda sürdürmektedir.
Araştırma sonucunda, fungus türlerinin ekstrem koşullara olan adaptasyon ve tercihleri ortaya konulacak; böylece bu organizmaların jeolojik süreçlerdeki yeri ve önemi daha iyi anlaşılacaktır. Bu çalışmanın, yüksek alkali özellik gösteren karasal bir ortamda jeomikoloji yaklaşımıyla gerçekleştirilen ilk araştırmalardan biri olması, projenin özgünlüğünü ve yenilikçi yönünü ortaya koymaktadır.
Bu kapsamda öğretim üyemiz, DISTAV Mikoloji Laboratuvarı’nda görev yapan uzman mikologlar ve doğa bilimcileri ile birlikte çalışmalarına devam etmekte ve aynı zamanda araştırma konusu ile ilgili olarak DISTAV bünyesinde seminerler vermektedir.
Fakültemiz olarak öğretim üyemizi tebrik ediyor, üniversitemizi uluslararası alanda temsil ettiği bu önemli çalışmasında başarılar diliyoruz.